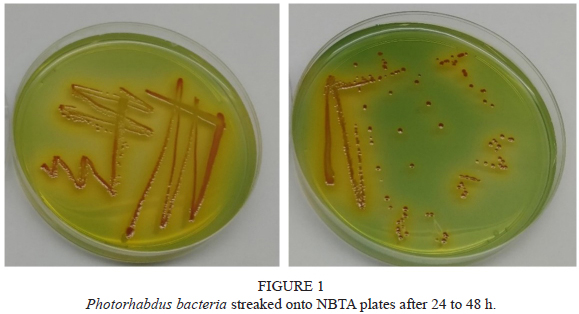

Services on Demand
Journal
Article
Indicators
Related links
-
Cited by Google -
Similars in Google
Share
South African Journal of Enology and Viticulture
On-line version ISSN 2224-7904Print version ISSN 0253-939X
S. Afr. J. Enol. Vitic. vol.45 n.2 Stellenbosch 2024
https://doi.org/10.21548/45-2-6571
ARTICLES
Selection of a South African Heterorhabditis bacteriophora Isolate for in vitro Liquid Mass Production for the Control of Thaumato-tibia leucotreta in Grapevine
N.J. Claasen; M.D. Dunn; A.P. Malan*
Department of Conservation Ecology and Entomology, Faculty of AgriSciences, Stellenbosch University, Private Bag X1, Matieland 7602, Stellenbosch, South Africa
ABSTRACT
The South African table grape industry requires biological control options for pest insects to maintain export relationships. Entomopathogenic nematodes (EPNs) have shown effective biological control of the economically important table grape pest, Thaumatotibia leucotreta, the false codling moth (FCM). Critical to the success of EPNs is their ability to be mass produced using in vitro liquid mass production methods. The selection of suitable isolates for mass production is the most important step in the process of developing an EPN biocontrol product for commercial purposes. Heterorhabditis bacteriophora is the most common EPN species found in South African soils, with previous research having shown its high pathogenicity against a variety of grapevine pest insects. In this study, four local H. bacteriophora isolates were laboratory-screened to select the best candidate in terms of virulence against FCM, and differences in the symbiotic bacteria isolates were also observed. Two of the H. bacteriophora isolates, CRI_LC and LLM's symbiotic Photorhabdus bacteria, showed slight bioluminescence, while SGI170 and Px_SPH showed strong luminescence, indicating the biological difference between the symbiotic bacterial species that are associated with the same nematode species. Molecular analysis of the 16S gene indicated three different bacterial species, of which two were the same and two are possibly new. The H. bacteriophora isolate, SGI_170, which showed the highest virulence against late-instar FCM larvae, was chosen for the further development of in vitro liquid culture.
Key words: Bioluminescence, false codling moth, grapevine, Heterorhabditis bacteriophora, virulence, Photorhabdus
INTRODUCTION
Thaumatotibia leucotreta (Meyrick) (Lepidoptera: Tortric-idae), the false codling moth (FCM), is a pest of economic importance in table grapes, especially in citrus orchards and stone fruit crops (Bloem et al., 2007). With regard to the table grape industry, South Africa was the fourth highest exporter of table grapes in the 2022 season, exporting over 400 000 tons (South African Table Grape Industry [SATI], 2023). Thus, the table grape industry influences aspects of South Africa's agricultural economy through international investments and import-export trade (World Citrus Organisation, 2022; SATI, 2023), making the control of FCM an important economic consideration. Because of environmental and human health-related issues with chemical pesticides used to control insect pests, the European Union, one of South Africa's biggest table grape and citrus export partners, has created laws that prohibit the use of certain chemical products. This has affected how South African farmers control FCM, as they can no longer use the same pesticide products they were using previously, and there are few products available in South Africa that meet the organic and environmentally friendly requirements for fruit produce export.
A specific life cycle stage of FCM leaves them vulnerable to parasitism from soil-dwelling biocontrol agents, such as entomopathogenic nematodes (EPNs), fungi and bacteria. FCM lay their eggs on the fruit and, once the eggs hatch, the larvae penetrate the fruit. The fifth-instar (last-instar) larvae emerge from the fruit and burrow into the soil, where they cocoon themselves with their silk mixed with soil debris, whereupon they are also exposed to soil entomopathogens (Daiber, 1979a, 1989). After two to three days, the prepupa in the cocoon turns into a pupa, with a further 12 to 14 days (depending on the prevailing temperature) in the soil before adults emerge from the cocoon and soil, continuing their life cycle above ground (Daiber, 1979b).
EPNs are natural enemies of insects. They occur naturally in the soil environment and are parasites of pest insects. They also pose no threat to humans and the environment, thus making them ideal to use as a biocontrol agent in an integrated pest management strategy (Surrey & Davies, 1996). EPNs are classified in the order Rhabditida and the families Steinernematidae, associated with the mutualistic Xenorhabdus bacteria, and Heterorhabditidae, associated with Photorhabdus bacteria. EPNs form complex bacto-helminthic relationships with their associated bacteria, which are key to their survival (Ehlers, 2001; Han & Ehlers, 2001). The free-living nonfeeding stage, the infective juvenile (IJ) stage, is an arrested third-stage juvenile and is adapted to adverse conditions in the soil while seeking for an insect host. Once the target host is found, the IJ enters the insect through such natural openings as the mouth or anus. Heterorhabditis has a dorsal tooth that allows it to penetrate the soft cuticle by means of abrasion (Surrey & Davies, 1996; Shapiro-Ilan & Gaugler, 2002). Once the EPN is inside the insect, the nematode releases its associated bacteria into the haemocoel of the insect, where the bacteria start to proliferate, killing the insect through induced septicaemia (Surrey & Davies, 1996; Shapiro-Ilan & Gaugler, 2002). A food signal is then released that induces the recovery of the IJs, whereupon they start to feed and emerge from their arrested nonfeeding (dauer) stage (Golden & Riddle, 1984; Ehlers et al., 2000). The bacteria also release a cocktail of metabolites that protect the insect cadaver in the soil environment and the internally developing nematodes. The IJs develop into third- and fourth-stage juveniles, and then to males and females in the case of Steinernema. In Heterorhabditis, the first generation is a self-fertilising hermaphroditic female, while the subsequent second generation produces amphimictic adults (females and males) (Hirao & Ehlers, 2010). The population then continues to grow until the food source is depleted, after which the second-stage juveniles stop feeding and go into an arrested IJ state (Hirao & Ehlers, 2010). The eggs that are retained inside the females develop into juveniles that feed on the mother, which is a process that is known as endotokia matricida, with the juveniles involved emerging as IJs (Hirao & Ehlers, 2010). The IJs then leave the host insect in search of another host, where the cycle continues.
Heterorhabditis bacteriophora are very effective against FCM at low concentrations of IJs (50 IJ/insect), as demonstrated in laboratory screening (Malan et al., 2011) and in semi-field trials (Malan & Moore, 2016; Steyn et al., 2019). Large-scale field trails with imported H. bacteriophora confirm their suitability for application in a systems approach to control FCM in South Africa (Moore, 2021; Moore et al., 2024). However, no local H. bacteriophora product is currently available, although an exotic registered product can be purchased (Hatting et al., 2019).
Even though EPNs can kill the host insect by releasing venomous proteins (Lu et al., 2017) and suppressing the host immune system, it is especially highly pathogenic in a synergistic association with the bacteria. As the bacteria also provide the nematodes with nutrition, the relationship between the EPN and its symbiotic bacteria is mutualistic (Ehlers, 2001).
Malan et al. (2011) conducted a survey to establish whether any local EPN species would be viable for use against FCM in citrus orchards. Six EPN species, namely Steinernema khoisanae Malan et al., Steinernema yirgalemense Nguyen et al., Steinernema citrae Stokwe et al., Heterorhabditis bacteriophora Poinar, Heterorhabditis zealandica Poinar and Heterorhabditis noenieputensis Malan et al., were identified as potential biocontrol agents against FCM in laboratory (Malan et al., 2011) and field conditions (Malan & Moore, 2016).
Even though many different indigenous EPN species effectively control the last-instar larvae of FCM in South Africa, H. bacteriophora is the most frequently isolated species in vineyards and citrus orchards. Heterorhabditis bacteriophora is currently registered as a biopesticide by River Bioscience in South Africa, making it a good candidate for the control of FCM, as well as for mass-culture production, with an abundance of literature available on the mass culture (Surrey & Davies, 1996; Yoo et al., 2000, 2001; Malan et al., 2006; Hatting et al., 2009; Cho et al., 2011; Upadhyay, 2015; Malan & Moore, 2016). However, a local isolate of H. bacteriophora has not yet been mass-produced in South Africa.
The aim of this study was to select a local South African isolate of H. bacteriophora from different localities based on their pathogenicity. Since virulence against FCM is the key criterium for selecting an EPN isolate, the research focused on identifying the H. bacteriophora isolate with the highest virulence against FCM. Because the symbiotic bacteria associated with H. bacteriophora may not be the same for each isolate, they were separately characterised, as they play a crucial role in pathogenicity.
MATERIALS AND METHODS
Source of insects and nematodes
Thaumatotibia leucotreta final-instar larvae were obtained from XSIT, Citrusdal, Western Cape. Larvae of Galleria mellonella L. (Lepidoptera: Phylaridae), the greater wax moth, were obtained from the Forestry and Agricultural Biotechnology Institute (FABI) at the University of Pretoria. Four isolates of H. bacteriophora were sourced from the Eastern Cape, Free State and Western Cape provinces of South Africa (Table 1).
Heterorhabditis bacteriophora isolate verification
A single IJ of H. bacteriophora was placed in a 10 μ! drop of DNA extraction master mix and then cut into pieces using a sterile insulin needle. The DNA extraction master mix consisted of 79 μl nuclease-free water, 20 μl lysis buffer (16 mM [NH4]2SO4, 67 mM Tris-HCl pH 8.8, 0.1% Tween-20) and 1 μl proteinase K. The tubes concerned were transferred to a thermocycler for DNA extraction (Malan et al., 2011). The Eppendorf tubes were placed in a thermocycler at 65°C for 1 h, which was followed by 95°C for 10 min, whereupon they were used for PCR amplification. Primers TW81 (1.25 μΓ) forward 5'-GTTTCCGTAGGTGAACCTGC-3' and AB28 (1.25 μl) reverse 5-5'-ATATGCTTAAGTTCAGCGGGT-3' were used for PCR amplification of the ITS region. To this, 5 μl nuclease-free water, 5 μl DNA and 12.5 μl KAPA master mix were added. The thermocycling conditions for the PCR protocol were an initial temperature of 95°C for 3 min, with the annealing conditions being 35 cycles at 95°C for 20 sec, 48°C for 20 sec and 72°C for 30 sec. The final extension was at 72°C for 5 min, after which the mix was placed on hold at 4°C. The DNA product was visualised using an ethidium bromide agar gel. PCR products were sent to the Central Analytical Service of Stellenbosch University for sequencing. Afterwards, the forward and reverse sequences generated were edited using CLC Main Workbench, version 21.0.5, together with the consensus sequence nBLAST function on NCBA, to verify the nematodes' identity.
Isolation of associated Photorhabdus symbiotic bacteria
The associated Photorhabdus symbiotic bacteria of each H. bacteriophora isolate were isolated using G. mellonella. The larvae were infected with the different EPN isolates, sealed in a Petri dish to avoid contamination, and stored at 28°C for exactly 18 h. After 18 h, the haemolymph was extracted from the larvae (while still alive) under sterile conditions and streaked onto NBTA [Nutrient Agar (Difco Laboratories), 0.0025% bromothymol blue, 0.04% 2,3,5-triphenyltetrazolium chloride] plates (Akhurst, 1980; Dunn et al., 2021). The plates were then sealed and stored at 28°C for 48 h to allow the bacteria to proliferate and form colonies. After 48 h, a single colony of the bacteria was added to 30 ml tryptic soy broth (TSB) flasks and placed on Junior orbital shakers at 140 rpm at 28°C for 48 h. The bacteria were then cryogenically preserved, using glycerol, which was added to the shake flasks (15% v/v), equating to 4.5 ml of glycerol per 30 ml flask. One ml of the glycerol-bacteria mixture was then transferred to the 1.5 ml Eppendorf tubes and stored at -80°C (Kaya & Stock, 1997; Dunn et al., 2021). To confirm that the correct bacteria were harvested, bacterial lawns were made using the harvested bacteria of each isolate's associated symbiotic Photorhabdus bacteria. The Wouts plates were then stored in a growth chamber at 28°C for two days. In vivo-produced IJs from each isolate (without any sterilisation) were added to their respective Wouts plates, with the presence of the bacteria being confirmed when the nematodes recovered (i.e., opened their mouths and started feeding) and were found to grow on the Wouts plates.
Identification of Photorhabdus
The symbiotic bacteria stored at -80°C were thawed, with 200 μ! of the bacteria being placed into 30 ml TSB flasks on an orbital shaker at 140 rpm for 48 h at 28°C. After 48 h, the bacteria were ready for use for molecular identification. The bacterial DNA was extracted from the TSB solution using the Xymo Research Quick-DNA™ Fungal/Bacterial Miniprep kit. To ensure that pure DNA was collected, 1 μl of the DNA was placed on a NanoDrop® ND-1000 UV-Vis spectrophotometer, which analyses the purity of the DNA concentrations in a visible UV wavelength range. The purity of the DNA was measured in the 260/280 column, with good purity ranges (A260/A280) of between 1.80 and 2.00 being achieved, with the procedure being repeated for each DNA sample. A polymerase chain reaction (PCR) analysis was then conducted on the symbiotic bacteria, with the 16S genes being targeted for amplification. The reaction components of the PCR analysis included a 5 μl Q5® reaction buffer, 0.5 μl dNTPs, 1.25 μl F8 (forward buffer), 1.25 μl R1512 (reverse buffer), 0.25 μl Q5® high-fidelity DNA polymerase, a 5 μl Q5® high QC enhancer, 11.5 μl nuclease-free water and 0.25 μl template (bacterial) DNA. The summation produced a 25 μl reaction, which could be scaled up, depending on the number of DNA samples involved. The thermocycling conditions for the PCR protocol were kept at an initial temperature of 98°C for 10 min, with the annealing conditions being 30 cycles of 98°C for 10 sec, 57°C for 30 sec and 72°C for 1 min. The final extension was conducted at 72°C for 7 min, after which it was placed on hold at 4°C. A post-PCR check was conducted for both the bacterial DNA and the nematode DNA. Once the presence of DNA bands was confirmed, the PCR product was sent to the Central Analytical Facilities (CAF) DNA Sequencing Unit at Stellenbosch University for sequencing.
Bioluminescence Photorhabdus isolates
The associated Photorhabdus symbiotic bacteria of each H. bacteriophora isolate were streaked onto NBTA plates and stored at 28°C for 48 h to allow colonies to form on the plates. After 48 h, a single colony was placed in TSB and incubated for 48 h at 28°C on an orbital shaker at 140 rpm. Once the bacteria had proliferated, 1 ml of the TSB-bacteria solution was placed into 24-well plates and bioluminescence was calibrated for each sample, using IVIS® Spectrum in vivo imaging.
Pathogenicity bioassay
Late-instar larvae of FCM were used to test the virulence of the different H. bacteriophora isolates. The five treatments used in the bioassay consisted of the four H. bacteriophora isolates that were selected from the surveys done, with a fifth control treatment consisting of distilled water. For each treatment, five 24-well bioassay plates were used. Whatman 12.7 mm disc filter papers were placed in each alternative well, with the FCM larvae then being placed in each filter paper-containing well. There were 12 FCM larvae per well plate, hence 60 FCM larvae per treatment in total. For the EPN treatments, each well was inoculated with a nematode inoculum of 50 IJs/50 whereas the control bioassay plates were inoculated with only 50 μl distilled water per well. The concentration formula was used to calculate the nematode inoculum density (Glazer & Lewis, 2000). The five 24-well bioassay plates of each treatment were placed in 2 L ice-cream containers, lined with moistened paper towels (moisture chamber) to ensure high humidity. The containers were then stored in a growth chamber at a controlled temperature of 25°C. The 24-well plates were checked for FCM mortality after 24 and 48 h. The FCM larvae were considered dead if they underwent a colour change and if they no longer moved when stimulated by gentle poking with forceps. FCM larvae in the EPN treatments that were dead were checked for infection by means of dissecting the larvae with the aid of a stereomicroscope. The dead FCM larvae with no EPNs present were considered to have died from natural causes. The bioassays with last-instar FCM larvae were repeated on a different test date with a fresh batch of each H. bacteriophora isolate.
Statistical analysis
No mortality occurred in the control group. The data pooled from the four isolates were analysed using R (R Core Team, 2023) and Statistica (TIBCO Software Inc., 2020). A normality test was performed prior to any analysis. The data were normally distributed once the control data had been removed from the pooled data. To determine significant difference among the mortality of the four isolates (treatments), a one-way analysis of variance (ANOVA) was done, with their interactions being significant at α < 0.05. A Fisher's least significant difference (LSD) test was used as a post-hoc analysis to determine which treatment groups had significant differences from one another.
RESULTS
Verification of Heterorhabditis isolates
The IJs of all four isolates were verified to be H. bacteriophora species, using the ITS region and the nBLAST function in GenBank. The sequences were submitted on GenBank H. bacteriophora isolate Px_SPH, with accession number OP856853, SGI170, with accession number OR347849, CRI_LC, with accession number OR347816, and LLM, with accession number OR350483. The identity of all isolates submitted on GenBank was a 100% match to H. bacteriophora.
Verification of Photorhabdus
The associated symbiotic Photorhabdus bacteria of each isolate streaked onto the NBTA plates displayed dark red to orange colonies (Fig. 1). The IJs of each isolate were successfully fed on bacterial lawns prepared on Wouts plates using their respective symbiotic Photorhabdus bacteria (Table 2). The bacteria for isolate LLM were identified as being Photorhabdus laumondii subsp. laumondii (FischerLe Saux et al.) Machado et al., whereas the CRI_LC isolate was identified, using next-generation sequencing, as a new species named Photorhabdus safricana Machado et al. (Machado et al., 2018, 2024). The bacteria of isolates Px_SPH and SGI170 were identified as likely being the same new species, using only the 16S gene (Table 2) and next-generation sequencing (R.R.A. Machado, personal communication).
Bioluminescence of Photorhabdus isolates
The bacteria of isolates Px_SPH (Western Cape) and SGI170 (Free State) were shown to be bioluminescent, whereas the isolates of CRI_LC (Eastern Cape) and LLM (Western Cape) showed low to no bioluminescence (Fig. 2).
Pathogenicity bioassay
Data from the two different test dates were analysed separately and, as no significant (p > 0.05) difference was found between the main effects of date and isolate, the data were pooled and analysed. A one-way ANOVA showed a significant difference (F3 36 = 11.254; p < 0.001) between the means of infection of FCM caused by the different isolates (Fig. 3). After 48 h, SGI170 had a mean infection rate of 75% ± 18.00%, CRI_LC had 55% ± 23.22%, LLM 44.15% ± 20.43% and Px_SPH 24.17% ± 14.93%. The infection of SGI170 was significantly higher (p < 0.001) than that of the other three isolates. No significant difference (p = 0.2338) was found between the means of the isolates CRI_LC and LLM. The isolate Px_SPH, which had the lowest infection percentage, was significantly lower (p < 0.05) than all the other isolates (Fig. 3). Colonies of the four Photorhabdus symbiotic bacteria showed red on NBTA, while the H. bacteriophora-infected wax moth larvae all had a similar dark red or brick-red colouration (Fig. 4).
DISCUSSION
Before selecting an EPN isolate for mass culture, it was regarded as being important to conduct a laboratory screening for pathogenicity, comparing not only EPN species, but also different isolates of the same species, to assess pathogenicity against the target pest insect. As H. bacteriophora is one of the most common EPN species found in South Africa (Malan et al., 2011) and one of the most successful commercially available nematode species (Heve et al., 2018; Modic et al., 2020), it has been selected as a potential species for mass-culture in South Africa.
The bacterial colonies of the fourPhotorhabdus symbiotic bacteria on the NBTA plates were all red, while the wax moth larvae, infected with the four different H. bacteriophora isolates, all had a similar dark red or brick-red colouration. Although the colour displayed by the EPN-infected wax moth larvae has been used to distinguish between different Photorhabdus subspecies for Heterorhabditis zealandica Poinar, the same cannot be done for the bacteria associated with H. bacteriophora (Booysen et al., 2022).
IVIS imaging of the bacteria in the TSB and on the agar plates showed differences between the Photorhabdus bacteria associated with each nematode isolate in terms of bioluminescence. Bioluminescence was found in two of the Photorhabdus symbionts (SGI170 and Px_SPH), while two only showed slight traces of bioluminescence (CRI-LC and LLM). Generally, all Photorhabdus species are assumed to show bioluminescence. However, another non-bioluminescent Photorhabdus was described as P. heterorhabditis subsp. aluminescens by Machado et al. (2021), named by the fact that it does not show any bioluminescence. A recent study by Cassells et al. (2024) demonstrates the potential for bioluminescence aposematism, combined with chemical defences produced by Photorhabdus, to deter slug scavengers from feeding on insect cadavers infected by bioluminescent bacteria.
Molecular analysis of the 16S gene further confirmed that the two low-luminescent bacteria were two different species, with one identified as P. safricana and the other as P. laumondii subsp. laumondii (Machado et al., 2024).
The other two bioluminescent isolates are an unknown, new Photorhabdus species. Recently, housekeeping genes and 16S RNA sequences were found not to be robust enough to identify Photorhabdus to species and subspecies level. Booysen et al. (2022) indicated the association of H. bacteriophora with seven different Photorhabdus species, including three subspecies of P. laumondii. All species of the Photorhabdus and H. bacteriophora combinations were associated with different countries. The results found by Booysen et al. (2022) concur with the results found in the present study, but with the same two unknown Photorhabdus occurring in different provinces (Western Cape and the Free State), and the two with low bioluminescence, P. laumondii subsp. laumondii (LLM) in the Western Cape and P. safricana in the Eastern Cape, occurring in citrus. In a previous study in South Africa, the symbiotic bacteria of H. bacteriophora isolate SF351 were identified as P. luminescens subsp. laumondii (Geldenhuys et al., 2016) from a vineyard in Wellington in the Western Cape, with the name being elevated by Machado et al. (2018) to P. laumondii subsp. laumondii. The result obtained agrees with the occurrence of the associated bacteria LLM found in apple orchards in the Western Cape.
The isolates SGI170 and Px_SPH of H. bacteriophora, from apple orchards in the Free State and the Western Cape, respectively, showed the highest infection (75%), whereas Px_SPH showed the lowest (24%). Although the two isolates concerned originated from different provinces in South Africa, they share the same unknown Photorhabdus isolate. A possible reason for the difference in pathogenicity may be ascribed to the fact that Px_SPH was recently isolated directly from a Phlyctinus xerophilus weevil, whereas SGI_170 was isolated directly from the soil and then recycled many times through wax moth larvae (Hatting et al., 2009; Hansen et al., 2023). The isolates CRI-LC and LLM share the same Photorhabdus species, P. laumondii, although with different subspecies. However, no significant difference was found in the pathogenicity between the two subspecies.
A low concentration (50 IJs/insect) of different H. bacteriophora isolates was used to obtain a good indication of the difference in pathogenicity between the four isolates with FCM larvae as the host. The infection rate of SGI170 was found to be in line with other studies with similar bioassay protocols (Geisert et al., 2023). Host insect susceptibility to EPN infection might also affect infectivity. FCM are susceptible to several EPNs, including S. yirgalemense, H. zealandica, Steinernema litchi Steyn et al. and Steinernema jeffreyense Malan et al. (Steyn et al., 2017, 2019). Laboratory bioassays conducted with such EPN species resulted in high mortality of >80% (Steyn et al., 2017, 2019), with such mortality rates all being higher than what was achieved in this study with H. bacteriophora. One explanation for such mortality rates could be that H. bacteriophora might have a lower infectivity rate compared to the other EPN species. However, due to the ubiquitous spread of H. bacteriophora across South Africa and its registration as a biopesticide, as well as due to the body of research that is currently available, H. bacteriophora is taken to be the species of choice for mass in vitro culture.
As with the study conducted by Steyn et al. (2017), 50 IJs/50 μ! were inoculated per well. Geisert et al. (2023) obtained a high mortality against corn rootworm larvae when inoculated with 60 IJs and 120 IJs per well, with between 80% and 100% mortality being obtained. Wells inoculated with 30 or fewer IJs had a mortality of < 50% (Geisert et al., 2023). From this, the inference can be made that inoculating a high number of IJs per well per larva would likely result in an increased mortality rate. The reason for isolates having reduced mortality could be that the FCM were less susceptible to infectivity compared to the other isolates concerned. The isolate with the second highest mortality was CRI_LC, at 50%.
The results of the present study indicate the importance of the different associated symbiotic bacteria associated with the same nematode species. Future studies should identify the associated bacteria of H. bacteriophora at both species and subspecies level, before comparing different isolates of the same species of H. bacteriophora with each other. Significantly, imported H. bacteriophora could be associated with different species of Photorhabdus, which could not be regarded as the same biological system, despite being identified as the same nematode species. The isolate SGI170, with its associated unknown Photorhabdus species of symbiotic bacteria, was selected for in vitro liquid mass-culture of H. bacteriophora in terms of virulence against FCM larvae during laboratory screenings. As the ease of in vitro mass culture is the second most important characteristic for in vitro liquid culture, the next step in this study should be to select between the two best-performing H. bacteriophora isolates.
LITERATURE CITED
Akhurst, R.J., 1980. Morphological and functional dimorphism in Xenorhabdus spp., bacteriasymbioticallyassociatedwiththeinsectpathogenic nematodes Neoaplectana and Heterorhabditis. Microbiology 121(2), 303-309. https://doi.org/10.1099/00221287-121-2-303 [ Links ]
Bloem, S., Carpenter, J. & Hofmeyr, H., 2007. Area-wide control tactics for the false codling moth Thaumatotibia leucotreta in South Africa: A potential invasive species. In: Vreysen, M.J.B., Robinson, A.S. & Hendrichs, J. (Eds.), Area-wide control of insect pests: From research to field implementation. Springer Netherlands, Dordrecht. pp. 351 - 359. [ Links ]
Booysen, E., Malan, A.P. & Dicks, L.M.T., 2022. Colour of Heterorhabditis zealandica-infected-Galleria mellonella dependent on the Photorhabdus symbiont, with two new nematode-symbiotic associations reported. J. Inverteb. Pathol. 189, 107729. https://doi.org/10.1016/jjip.2022.107729 [ Links ]
Cassells, M.D., Labaude, S. & Griffin, C.T., 2024. Beware glowing cadavers: Bioluminescence of nematode symbiont Photorhabdus protects nematode-infected host cadavers from nocturnal scavengers. Front. Ecol. Evol. 11, 1264251. https://doi.org/10.3389/fevo.2023.1264251 [ Links ]
Cho, C.H., Whang, K.S., Gaugler, R. & Yoo, S.K., 2011. Submerged monox-enic culture medium development for Heterorhabditis bacteriophora and its symbiotic bacterium Photorhabdus luminescens: Protein sources. J. Micro-biol. Biotechnol. 21(8), 869-873. https://doi.org/10.4014/jmb.1010.10055 [ Links ]
Daiber, C.C., 1979a. A study of the biology of the false codling moth [Cryptophlebia leucotreta (Meyr.)]: The larva. Phytophylactica 11(3), 141144. [ Links ]
Daiber, C.C., 1979b. A study of the biology of the false codling moth [Cryptophlebia leucotreta (Meyr.)]: The cocoon. Phytophylactica 11(4), 151-157. [ Links ]
Daiber, C.C., 1989. The false codling moth, Cryptophlebia leucotreta (Meyr.) (Lepidoptera, Tortricidae), in Southern Africa. J. Plant Dis. Prot. 96, 71-80. [ Links ]
Dunn, M.D., Belur, P.D. & Malan, A.P., 2021. A review of the in vitro liquid mass culture of entomopathogenic nematodes. Biocontr. Sci. Technol. 31(1) 1-21. https://doi.org/10.1080/09583157.2020.1837072 [ Links ]
Ehlers, R.-U., 2001. Mass production of entomopathogenic nematodes for plant protection. Appl. Microbiol. Biotechnol. 56, 623-633. https://doi.org/10.1007/s002530100711 [ Links ]
Ehlers, R.-U., Niemann, I., Hollmer, S., Strauch, O., Jende, D., Shanmu-gasundaram, M., Mehta, U.K., Easwaramoorthy, S.K. & Burnell, A., 2000. Mass production potential of the bacto-helminthic biocontrol complex Het-erorhabditis indica - Photorhabdus luminescens. Biocontrol Sci. Technol. 10(5), 607-616. https://doi.org/10.1080/095831500750016406 [ Links ]
Geisert, R.W., Huynh, M.P., Pereira, A.E., Shapiro Ilan, D.I. & Hibbard, B.E., 2023. An improved bioassay for the testing of entomopathogenic nematode virulence to the western corn rootworm (Diabrotica virgifera virgifera) (Coleoptera: Chrysomelidae): With focus on neonate insect assessments. J. Econ. Entomol. 116(3), 1-7. https://doi.org/10.1093/jee/toad052 [ Links ]
Geldenhuys, J., Malan, A.P. & Dicks L.M.T., 2016. First report of the isolation of the symbiotic bacterium Photorhabdus luminescens subsp. laumondii associated with Heterorhabditis safricana from South Africa. Curr. Microbiol. 73(6), 790-795. https://doi.org/10.1007/s00284-016-1116-7 [ Links ]
Glazer, I. & Lewis, E. E. 2000. Bioassays for entomopathogenic nematodes. In Navon, A. & Ascher, K.R.S. (eds). Bioassays of entomopathogenic microbes and nematodes. CABI, Wallingford. pp. 229 - 247. [ Links ]
Golden, J.W. & Riddle, D.L., 1984. The Caenorhabditis elegans dauer larva: Developmental effects of pheromone, food, and temperature. Dev. Biol. 102(2), 368-378. https://doi.org/10.1016/0012-1606(84)90201-X [ Links ]
Han, R. & Ehlers, R.-U., 2001. Effect of Photorhabdus luminescens phase variants on the in vivo and in vitro development and reproduction of the entomopathogenic nematodes Heterorhabditis bacteriophora and Steinernema carpocapsae. FEMS Microbiol. Ecol. 35(3), 239-247. https://doi.org/10.1111/j.1574-6941.2001.tb00809.x [ Links ]
Hansen, S.P., Malan, A.P., Haran, J.M. & Addison, P., 2023. Susceptibility of adult Phlyctinus (Coleóptera: Curculionidae) to entomopathogens: A first look at potential differences in a newly revised species complex. J. Appl. Entomol. 148, 129-139. https://doi.org/10.1111/jen.13214 [ Links ]
Hatting, J.L., Moore, S.D. & Malan, A.P., 2019. Microbial control of phytophagous invertebrate pests in South Africa: Current status and future prospects. J. Invertebr. Pathol. 165, 54-66. https://doi.org/10.1016/j.jip.2018.02.004 [ Links ]
Hatting, J., Stock, S.P. & Hazir, S., 2009. Diversity and distribution of entomopathogenic nematodes (Steinernematidae, Heterorhabditidae) in South Africa. J. Invertebr. Pathol. 102(2), 120-128. https://doi.org/10.1016/j.jip.2009.07.003 [ Links ]
Heve, W.K., El-Borai, F.E., Johnson, E.G., Carrillo, D., Crow, W.T. & Duncan, L.W., 2018. Responses of Anastrepha suspensa, Diachasmimorpha longicaudata, and sensitivity of guava production to Heterorhabditis bacteriophora in fruit fly integrated pest management. J. Nematol. 50(3), 261-272. https://doi.org/10.21307/jofnem-2018-039 [ Links ]
Hirao, A. & Ehlers, R.-U., 2010. Influence of inoculum density on population dynamics and dauer juvenile yields in liquid culture of biocontrol nematodes Steinernema carpocapsae and S. feltiae (Nematoda: Rhabditida). Appl. Microbiol. Biotechnol. 85, 507-515. https://doi.org/10.1007/s00253-009-2095-4 [ Links ]
Kaya, H.K. & Stock, S.P., 1997. Techniques in insect nematology. In Lacey, L. (ed.). Manual of techniques in insect pathology. Academic Press, Cambridge, MA. pp. 281 - 324. [ Links ]
Lu, D., Macchietto, M., Chang, D., Barros, M.M., Baldwin, J., Mortazavi, A. & Dillman, A.R., 2017. Activated entomopathogenic nematode infective juveniles release lethal venom proteins. PloS Pathog. 13(4), e1006302. https://doi.org/10.1371/journal.ppat.1006302 [ Links ]
Machado, R.R.A, Malan, A.P., Boss, A., Claasen, N.J., Bhat, A.H. & Abolafia, J., 2024. Photorhabdus africana sp. nov. isolated from Heterorhabditis entomopathogenic nematodes. Int. J. Syst. Evol. Microbiol. 81(8), 240. https://doi.org/10.1007/s00284-024-03744-3 [ Links ]
Machado, R.A.R., Muller, A., Ghazal, S.M., Thanwisai, A., Pagès, S., Bode, H.B., Hussein, M.A., Khalil, K.M. & Tisa, L.S., 2021. Photorhabdus heterorhabditis subsp. aluminescens subsp. nov., Photorhabdus heterorhabditis subsp. heterorhabditis subsp. nov., Photorhabdus australis subsp. thailandensis subsp. nov., Photorhabdus australis subsp. australis subsp. nov., and Photorhabdus aegyptia sp. nov. isolated from Heterorhabditis entomopathogenic nematodes. Int. J. Syst. Evol. Microbiol. 71(1), 4610. https://doi.org/10.1099/ijsem.0.004610 [ Links ]
Machado, R.A.R., Wüthrich, D., Kuhnert, P., Arce, C.C.M., Thönen L., Ruiz, C., Zhang, X., Robert, C.A.M., Karimi, J., Kamali, S., Ma, J., Bruggmann, R. & Erb, M., 2018. Whole-genome-based revisit ofPhotorhabdus phylogeny: Proposal for the elevation of most Photorhabdus subspecies to the species level and description of one novel species Photorhabdus bodei sp. nov., and one novel subspecies Photorhabdus laumondii subsp. clarkei subsp. nov. Int. J. Syst. Evol. Microbiol. 68(8), 2664-2681. https://doi.org/10.1099/ijsem.0.002820 [ Links ]
Malan, A.P. & Moore, S.D., 2016. Evaluation of local entomopathogenic nematodes for the control of false codling moth, Thaumatotibia leucotreta (Meyrick, 1913), in a citrus orchard in South Africa. Afr. Entomol. 24(2), 439-501. https://doi.org/10.4001/003.024.0489 [ Links ]
Malan, A.P., Knoetze, R. & Moore, S.D., 2011. Isolation and identification of entomopathogenic nematodes from citrus orchards in South Africa and their biocontrol potential against false codling moth. J. Invertebr. Pathol. 108(2), 115-125. https://doi.org/10.1016/j.jip.2011.07.006 [ Links ]
Malan, A.P., Nguyen, K.B. & Addison, M.F., 2006. Entomopathogenic nematodes (Steinernematidae and Heterorhabditidae) from the southwestern parts of South Africa. Afr. Plant Prot. 12(1), 65-69. https://doi.org/10.10520/EJC87795 [ Links ]
Modic, S., Zigon, P., Kolmanic, A., Trdan, S. & Razinger, J., 2020. Evaluation of the field efficacy of Heterorhabditis bacteriophora Poinar (Rhabditida: Heterorhabditidae) and synthetic insecticides for the control of western corn rootworm larvae. Insects 11(3), 202. https://doi.org/10.3390/insects11030202 [ Links ]
Moore, S.D. 2021. Biological control of a phytosanitary pest (Thaumatotibia leucotreta): A case study. Int. J. Environ. Res. Public Health 2021, 18(3), 1198. https://doi.org/10.3390/ijerph18031198 [ Links ]
Moore, S.S., Ehlers, R-U., Manrakhan, A., Gilbert, M., Kirkman, W., Daneel, J.-H., De Waal, J.Y., Nel, R., Sutton, G. & Malan, A.P. 2024. Field-scale efficacy of entomopathogenic nematodes to control false codling moth, Thaumatotibia leucotreta (Lepidoptera: Tortricidae), in citrus orchards in South Africa. Crop Prot. 179, 106610. https://doi.org/10.1016/j.cropro.2024.106610 [ Links ]
R Core Team, 2023. R: A language and environment for statistical computing. R Foundation for Statistical Computing, Vienna. https://www.R-project.org/ [ Links ]
Shapiro-Ilan, D.I. & Gaugler, R., 2002. Production technology for entomopathogenic nematodes and their bacterial symbionts. J. Ind. Microbiol. Biotechnol. 28(3), 137-146. https://doi.org/10.1038/sj/jim/7000230 [ Links ]
South African Table Grape Industry (SATI), 2023. Statistics of table grapes in South Africa. SATI, Paarl. [ Links ]
Steyn, V.M., Malan, A.P. & Addison, P., 2019. Control of false codling moth, Thaumatotibia leucotreta (Lepidoptera: Tortricidae), using in vitro- cultured Steinernema jeffreyense and S. yirgalemense. Biol. Control 138, 104052. https://doi.org/10.1016/j.biocontrol.2019.104052 [ Links ]
Steyn, W.P., Malan, A.P., Daneel, M.S. & Slabbert, R.M., 2017. Entomopathogenic nematodes from north-eastern South Africa and their virulence against false codling moth, Thaumatotibia leucotreta (Lepidoptera: Tortricidae). Biocontrol Sci. Technol. 27(11), 1265-1278. https://doi.org/10.1080/09583157.2017.1391174 [ Links ]
Surrey, M.R. & Davies, R.J., 1996. Pilot-scale liquid culture and harvesting of an entomopathogenic nematode, Heterorhabditis bacteriophora. J. Invertebr. Pathol. 67(1), 92-99. https://doi.org/10.1006/jipa.1996.0013 [ Links ]
TIBCO Software Inc., 2020. Data Science Workbench, version 14. http://tibco.com [ Links ]
Upadhyay, D., 2015. Lab-scale in vitro mass production of the entomo-pathogenic nematode Heterorhabditis bacteriophora using liquid culture fermentation technology. Am. J. Biosci. Bioeng. 3(6), 203-307. https://doi.org/10.11648/j.bio.20150306.19 [ Links ]
World Citrus Organisation, 2022. Citrus world statistics. WCO, Brussels. [ Links ]
Yoo, S.K., Brown, I. & Gaugler, R., 2000. Liquid media development for Heterorhabditis bacteriophora: Lipid source and concentration. Appl. Microbiol. Biotechnol. 54(6), 759-763. https://doi.org/10.1007/s002530000478 [ Links ]
Yoo, S.K., Randy, G. & Christopher, W.B., 2001. Growth optimization of Photorhabdus luminescens isolated from entomopathogenic nematode Heterorhabditis bacteriophora. Microbiol. Biotechnol. Lett. 29(2), 104-109. [ Links ]
Accepted for publication: October 2024
* Corresponding author: apm@sun.ac.za
Acknowledgements: This study was funded by Citrus Research International (CRI) and D.G. Nel, from the Centre of Statistical Consultation, Stellenbosch, South Africa, for assistance with statistical analysis.












